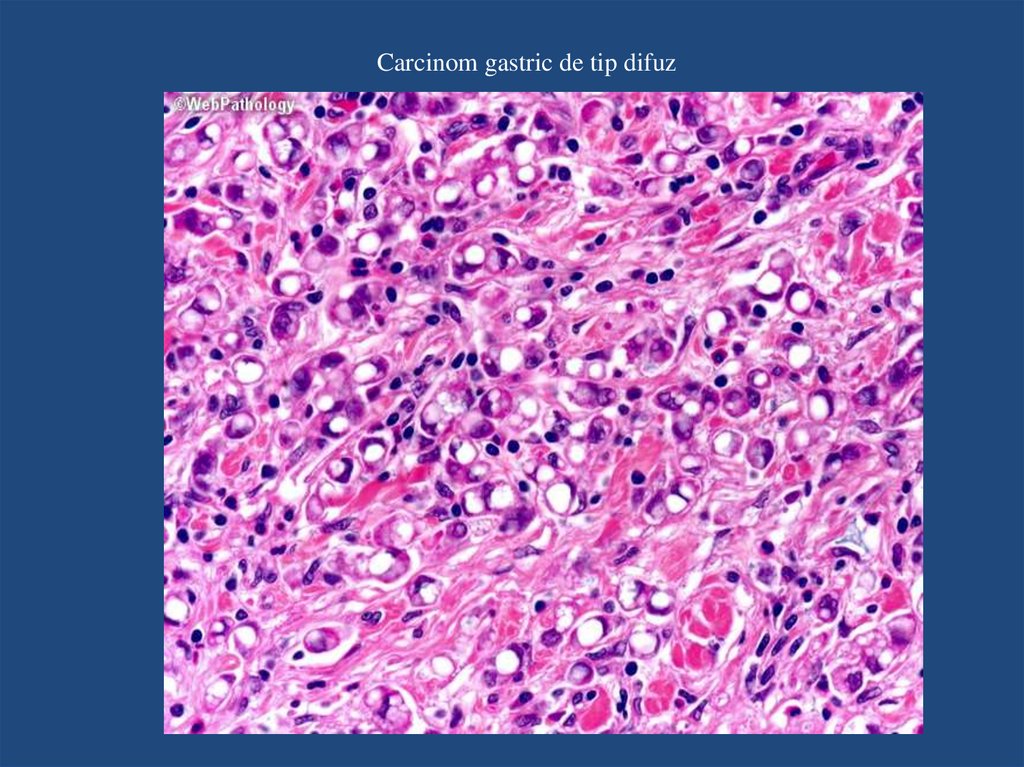

Similar presentations:
Patologia aparatului digestiv lp 3
1. PATOLOGIA APARATULUI DIGESTIV LP 3
2. ULCERUL GASTRIC
Ulcerul: afectiune cronica, ulcerativa, recidivanta, caracterizata histologic prin pierdere de substanta ( excavatie ) lanivelul mucoasei tractului gastro-intestinal, ce se extinde dincolo de musculara mucoasei in submucoasa si chiar mai
profund, in musculara propria, aparuta in urma actiunii consecutive agresive a sucului gastric asupra mucoasei.
- localizare: - duoden - segmentul I ( bulb, peretele anterior ) – mai frecvent;
- stomac ( pe zonele nesecretante de HCL – mai frecvent pe mica curbura, in partea mijlocie );
- Ud:Ug = 4:1
- frecvent unic / multiplu ( sdr. Zollinger Ellison );
- apare la orice varsta, mai frecvent la cei de varsta medie, barbati > femei;
Patogenie:
- dezechilibru intre factorii locali de aparare si factorii de agresiune ai mucoasei gastrice.
Factori protectori: - mucusul si bicarbonatul: rezistenta apicala a celulei epiteliale;
- celulele regenerate ( capacitatea de regenerare a epiteliului );
- PG
- fluxul sanguin corespunzator;
Factori agresivi: - principali: - acidul gastric
- pepsina
- Helicobacter pylori ( HP )
- secundari: - AINS, aspirina
- refluxul gastro-duodenal
- fumatul
Factori favorizanti: - gastrita antrala cronica;
- factorul ereditar: boala familiala ( grupa sanguina 0 );
3.
Macroscopic:Ulcer ( lipsa de substanta ) = Nisa ulceroasa.
1. forma: rotunda / ovalara, bine delimitata; 0,6 - > 4 cm;
( DD: eroziunea ( exulceratie ) < 0,3 cm si nu depaseste musculara mucoasei );
- cel mai mic de 4 cm are axul lung paralel cu mica curbura;
- cel mai mare de 4 cm are axul lung perpendicular pe mica curbura.
2. marginile:
- elevate / nu, netede ( hiperemiate in ulcerul acut );
- pliurile mucoasei din jur converg radiar spre nisa;
- mucoasa din jur este edematiata si congestiva ( datorita gastritei prezente );
( DD: ulcerul malignizat );
3. peretii: duri, relativ drepti:
- peretele proximal, dinspre cardia: drept;
- peretele distal, dinspre pilor: serpuit, “coboara in trepte”, ( datorita
contractiei muscularei mucoasei );
Nisa ulceroasa
4. adancimea: variaza
- ulcerul superficial: depaseste mucoasa si musculara mucoasei;
- ulcerul profund: depaseste musculara propria / tot peretele = baza ulceratiei
poate adera de pancreas, oment, ficat si pot apare perforari in cavitatea
peritoneala: peritonita;
5. baza:
- neteda, curata, gri-rosiatica ( tesut de granulatie ), uneori, cheaguri de sange;
Ulcer malignizat: margini ingramadite, aspect de
“matanii”, baza murdara cu necroza, aspra;
4.
Diagnostic de organ: stomac - organ cavitar format din 4 straturi:I. Mucoasa:
1. epiteliul de acoperire: unistratificat, cilindric secretor dispus pe membrana
bazala;
- celulele au nucleul bazal, alungit si citoplasma cu mucina situata supranuclear,
apical.
2. foveolele gastrice ( falduri / cripte ): invaginari ale epiteliului de suprafata in
lamina propria;
- sunt adanci cu lumen larg la nivel cardial si piloric ( antral ), ocupand
aproape jumatate din grosimea mucoasei;
• - sunt scurte cu lumen ingust la nivelul fundului / corpului gastric, ocupand
doar 25 % din grosimea mucoasei;
3. glandele gastrice: baza foveolelor.
4. lamina propria ( corion ): tesut conjunctiv lax, fibroblaste, mastocite,
macrofage, limfocite, plasmocite, vase;
• ! foliculii limfoizi sunt absenti ( prezenta lor / limfocite dispuse difuz este
intotdeauna patologica = semn indirect de Helicobacter Pylori ).
• ! PMN absente;
4. musculara mucoasei: fibre musculare netede in strat continuu, bine delimitate;
II. Submucoasa:
- tesut conjunctiv dens ( bogat in fibre ), vase sanguine si limfatice, plexul nervos
Meisner.
! nu contine glande.
III. Musculara:
- fibre musculare netede dispuse longitudinal, circular si oblic, plexul nervos
mienteric Auerbach.
IV. Seroasa:
- peritoneul visceral ( mezoteliu dispus pe o mb. subtire si tesut conjunctiv lax );
Zona pilorica
Zona fundica
5.
Microscopic: absenta mucoasei in zona de ulceratie.I. Baza ulceratiei – evolutie: 4 zone, dinspre mucoasa spre
seroasa ( dinspre zona superficiala spre zona profunda ):
1. exsudat fibrino-leucocitar ( PMN ), detritusuri celulare.
2. zona subtire de necroza fibrinoida, subiacent cu infiltrat
inflamator limfo-plasmocitar.
3. tesut de granulatie, cu fibroblaste si capilare de
neoformatie si infiltrat limfo-plasmocitar;
4. tesut fibros: fibroza solida ( cicatrice fibroasa /
colagenoasa ), vase cu pereti ingrosati ( datorita inflamatiei
din jur ), uneori trombozate.
II. Marginile ulceratiei:
1. hiperplazie de celule epiteliale ( hiperplazie vicarianta ),
cu limfo-plasmocite in lamina propria;
2. leziuni de gastrita cronica: limfo-plasmocite, PMN intraepiteliale ( inflamatie activa ), foliculi limfoizi,
Helicobacter pylori prezent, metaplazie intestinala ( factor
de risc pt aparitia ADK gastric ), celule epiteliale displazice;
3. musculara mucoasei: intrerupta, fuzata cu musculara
propria.
4. pot apare leziuni regenerative ale epiteliului ( leziuni
reactive ): celule mai mari, cu citoplasma eozinofila, lipsita
de mucina, cu nucleu mare dispus central;
6. Ulcer peptic
Helicobacter Pylori ( coloratie: albastru alcian / Giemsa )7.
DD:1. Ulcerul peptic recent
- nisa ulceroasa: mica curbura;
- forma ovala, cu margini nete, abrupte si baza curata, gri-verzuie;
Microscopic: leziunea este doar la nivelul mucoasei ( ulcer superficial ).
2. Ulcerul pe cale de vindecare
- aspect de zona albicioasa ( cicatrice retractila ) la nivelul mucoasei spre care, pliurile mucoasei gastrice din jur converg
in stea;
- localizat la nivel piloric: produce dilatatie gastrica in amonte;
- localizat la nivelul micii curburi: stomacul are aspect bilocular / “stomac in clepsidra”;
Microscopic: baza ulceratiei este formata din tesut de granulatie pana la nivelul mucoasei iar, epiteliul de suprafata din
marginea ulcerului acopera zona de ulcer formand o mucoasa subtire, neteda si alba.
3. Ulcerul de stress ( ulcerul acut ): frecvent multiplu.
- apare mai frecvent in regiunea fundica a stomacului, de forma rotunda, mic, ( < 1 cm ); marginile hiperemiate si baza
sunt moi, neindurate; baza este bruna, acoperita de fibrina si hematii;
! ulcerele simultane ( gastric, duodenal si esofagian ) apar la cei cu operatii, tumori, leziuni intracraniene: Ulcere
Cushing.
! ulcerele duodenale ( bulb ) apar la cei cu arsuri severe / traumatisme: Ulcere Curling.
Microscopic:
- denudarea epiteliului de suprafata, sufuziuni sanguine in mucoasa si in submucoasa, infiltrat inflamator acut ( PMN );
- absenta fibrozei si a peretilor vasculari ingrosati;
4. Cancerul gastric - forma ulceroasa
- depresiune crateriforma a mucoasei, cu margini ingrosate, neregulate ( anfractuoase ), aspect de “matanii” si baza
murdara cu zone de necroza si hemoragie.
8.
Complicatii:1. Hemoragia
- cea mai frecventa complicatie; 15-20 % din cazuri;
- prezenta hemoragiei: indica primul semn de ulcer;
- datorata erodarii vaselor din baza focarului ulceros ( clinic: hematemeza, melena, hemoragie oculta );
2. Perforatia
- 5 % din cazuri; foarte rar este primul semn de ulcer;
- mai frecventa in cazul ulcerului duodenal ( perete anterior );
- cea mai grava complicatie, pentru ca:
• peritoneu: peritonita;
• pancreas: rara, fatala.
3. Obstructia
- frecvent: ulcerul piloric, ulcerul duodenal;
- prin edem, cicatrizare, cu formare de stenoza pilorica / duodenala si consecutiv dilatarea stomacului.
4. Dureri retractare
5. Malignizarea
9. GASTRITA MICOTICA
Definitie: inflamatie subacuta, specifica, micotica a mucoasei si submucoasei gastrice, insotitafrecvent de enterita.
- apare la persoanele imunodepresive / dupa tratamente antibiotice cu spectru larg, fara protectie
antimicotica;
Macroscopic:
- pe suprafata mucoasei gastrice sunt prezente depozite albicioase - galbui, mici, rotunde, cu
margini proeminente dispuse difuz, moi, ( detritus grunjos, alb-galbui ), usor detasabile, cu
producerea de eroziuni ( exulceratii ) ale mucoasei gastrice;
10.
Microscopic:1. Epiteliul:
- eroziuni ( exulceratii ) ale epiteliului de
suprafata acoperite de spori, pseudohife si
hife ( filamente ) Candida ( colorate in rosu
cu PAS - periodic acid Schiff ) dispuse
uneori plexiform.
- uneori granuloame fungice cu focare
supurative centrale ( preponderent PMN );
- detritusuri celulare, zone reduse de
necroza, cu celule inflamatorii;
2. Lamina propria:
- infiltrat inflamator mixt, subacut:
limfocite, plasmocite, PMN.
- coloniile fungice pot apare si in cadrul
ulcerului gastric, in detritusul necrotic.
11. GASTRITA MICOTICA
HE x10PAS x20
12. CARCINOMUL GASTRIC MUCIPAR
Definitie: TM epiteliala a mucoasei gastrice, frecvent cu diferentiere glandulara ( ADK ), ce urmeazafrecvent unei gastrite cronice atrofice.
- este a II-a TM ca frecventa, dupa carcinomul scuamos pulmonar.
- este mai frecvent la barbati, intre 40-50 de ani;
Localizare: - de predilectie pe mica curbura si regiunea pilorica ( canal / antru piloric );
- mai rar: - pe marea curbura ( langheta de mucoasa antrala extinsa la marea curbura );
- cardia ( jonctiunea esofago-gastrica ), versantul gastric de mucoasa esofagiana;
Macroscopic: masa tumorala, de dimensiuni variabile ( 1 - 15 cm );
- dupa criteriile Borrmann, cancerul gastric poate fi:
1. polipoid: TM mai mica, ~ unui polip, ce protruzeaza in lumenul gastric.
2. vegetant / conopidiform: masa tumorala cu suprafata neregulata, reliefata, sangeranda, cu aspect de
“cancer in farfurie”.
3. ulcerativ: excavat, cu margini neregulate, inghesuite, anfractuoase, 2 – 10 cm, baza murdara cu necroza
si hemoragie.
4. infiltrativ: difuz, in toata grosimea peretelui gastric, numit “linita plastica”, stomac de aspect tubular,
peretele fiind dur si ingrosat; TM se intinde pe o portiune variabila, cu o usoara denivelare a mucoasei in
zona tumorii.
ADK mucinos: masa tumorala are aspect gelatinos, cu suprafata de sectiune translucida, culoare galbuie;
13.
Carcinomul gastricForma polipoida
Forma vegetanta
Forma ulceroasa, crateriforma
Linita plastica: mucoasa erodata cu perete ingrosat.
14.
Microscopic: conform clasificarii Lauren: 2 tipuri:- adenocarcinom ( ADK ) gastric de tip intestinal
- carcinom gastric de tip difuz;
1. ADK gastric de tip intestinal:
Macroscopic: tip polipoid / vegetant
- b > f, ~ 55ani;
- metastaze: ficat ( cale hematogena );
1. Glandele tumorale:
- glande tumorale de tip intestinal ( ~ cu cele din ADK colon ), neregulate,
inghesuite, unele alipite, de marimi diferite, lipsite de membrana bazala.
Celulele tumorale: pot forma si cordoane celulare care, tind sa impinga marginea T
in peretele gastric.
- este invaziv: - mucoasa, submucoasa: cancer precoce;
- musculara, seroasa: cancer avansat;
Celulele tumorale: au citoplasma abundenta, eozinofila cu vacuole de mucina la
nivel apical, nuclei mariti de volum, inghesuiti, intens hipercromi, pleomorfi,
cromatina grunjoasa, mitoze atipice prezente;
- lumenul glandelor tumorale: mucina / fara mucina, necroza / nu;
- cand cantitatea de mucina intraluminala / interstitiala depaseste 50 % din suprafata:
ADK gastric de tip mucinos;
- este ADK gastric bine diferentiat ( G1 ), cu pattern de crestere intins;
- asociat intotdeauna cu metaplazie intestinala;
2. Stroma:
- marcat infiltrat inflamator limfo-plasmocitar, PMN;
15.
ADK gastric de tip intestinal16.
2. Carcinomul gastric de tip difuz:Macroscopic: tip ulcerativ, infiltrativ ( linita plastica );
- f > b, ~ 48 ani;
- metastaze: pe cale limfatica, mai frecvent in:
1. in ggl. regionali;
2. in ovare ( bilateral ): Tumora Krukenberg;
1. Celulele tumorale:
- nu formeaza glande;
- sunt izolate ( discoezive ) si se dispun difuz in mucoasa
si infiltreaza peretele gastric ( submucoasa, musculara,
seroasa );
- pot forma mici cuiburi de celule.
- celulele tumorale au citoplasma palida, cu mucina
abundenta ce impinge nucleul la periferie, aspect “inel
cu pecete”, mitoze putine;
- carcinom gastric slab diferentiat ( G3 );
- metaplazia intestinala nu este obligatorie.
2. Stroma:
- reactie desmoplazica a stromei mai pronuntata decat in
cel de tip intestinal, cu fibroza prezenta ( rigiditatea
locala a peretelui );
17.
Carcinom gastric de tip difuz18.
Toate carcinoamele gastrice, indiferent de clasificare si variante pot fi invazive:- din aproape in aproape ( invadarea seroasei ): diseminare peritoneala;
- cale limfatica: metastaze locale;
- cale hematogena: metastaze la distanta;
Metastaze locale: duoden, pancreas, retroperitoneal;
Metastaze la distanta: ficat, plamani, ovare ( bilateral ): T. Krukenberg = carcinom cu
celule “in inel cu pecete”;
Frecvent:
1. ggl. santinela supraclavicular Wirchow ( prima manifestare a unui neoplasm
gastric ocult );
2. regiunea periombilicala: nodul subcutanat, “nodulul Sister Mary Joseph”
( marker pentru metastaza de carcinom );
19. ENTERITA ULCERO-NECROTICA
Definitie: inflamatie acuta a intestinului subtire, distrofica, ulcerativa, ce afecteaza doar mucoasaintestinala si mai rar submucoasa;
Etiologie:
- bacteriana invaziva: Salmonella, Shigella ( Gram - ), Campylobacter jejuni;
- bacteriana toxigenica: Clostridium botulinum, Stafilococul auriu, Escherichia Coli;
- la prematuri, la cei imunodeficitari ( propria flora intestinala ); ( incompetenta imunologica );
- idiopatica;
Clinic: sindrom diareic ( mucus, puroi si sange );
Macroscopic:
Mucoasa: hiperemiata, edematiata cu leziuni ulcerative ( lipsa de substanta ), necrotice, galben murdare,
de contur regulat / neregulat inconjurate de un lizereu rosu, unice / frecvent multiple dispuse izolat /
confluente denudand arii largi;
- zone de mucoasa reziduala ( aspect de pesudopolipi );
- hiperplazie de tesut limfoid;
- uneori, pot apare pseudomembrane alb-glabui cu exsudat hemoragic ( Clostridium botulinum ).
Seroasa: normala / acoperita de exsudat seros / fibrinos / hemoragic.
- leziunile pot apare si la nivelul colonului ( cec = tiflita; colon ( sigmoid / descendent ) = colita, tot
colonul = pancolita, rect = proctita );
20.
Enterita ulcero-necrotica21.
Diagnostic de organ: IS - organ cavitar, 4 straturi:I. Mucoasa:
1. vilozitati intestinale: proeminente digitiforme
intraluminale ale mucoasei cu ax conjunctivo - vascular
tapetate de epiteliu cilindric unistratificat dispus pe
membrana bazala, format din celule de absorbtie
predominant si putine celule caliciforme ( celule Goblet ) ce
contin picaturi de mucus;
- celulele de absorbtie prezinta la polul apical microvili ce
formeaza “marginea in perie”.
2. corion ( lamina propria ): tesut conjunctiv lax, bogat
celular ( fibroblaste, limfocite, plasmocite ), glande
intestinale Lieberkuhn dispuse la baza vilozitatilor, tapetate
de epiteliu cilindric unistratificat.
3. musculara mucoasei: fibre musculare netede;
Duoden: mucoasa;
II. Submucoasa: tesut conjunctiv lax, limfo-plasmocite,
vase, filete nervoase ( plexul Meissner ), foliculi limfoizi.
III. Musculara: groasa, fibre musculare netede dispuse
longitudinal si circular; plexul nervos Auerbach.
IV. Seroasa: peritoneul visceral - tesut conjunctiv lax,
acoperit de mezoteliu dispus pe membrana bazala.
Ileon: mucoasa;
22.
Jejun: mucoasa;Jejun: mucoasa;
23.
Microscopic:1. La nivelul mucoasei: pierdere de substanta pana la
nivelul muscularei mucoasei uneori, pana in submucoasa
( reflecta caracterul necrotic ulcerativ ).
- lumen: necroza cu PMN si hematii.
- PMN intraepiteliale: in epiteliul de suprafata sau al
glandelor ( criptite ) si in lumenul criptelor ( abcese
criptice ) - semn de boala activa;
- lamina propria: infiltrat inflamator limfo-plasmocitar
discret, PMN;
- vase hiperemiate;
2. Submucoasa: hiperemie, edem, hemoragie;
- infiltrare cu PMN si limfocite;
3. Seroasa: uneori, reactie inflamatorie;
- in faza de remisie a fazei active: tesut de granulatie, ce
umple zona de ulceratie, urmat de regenerarea epiteliului
mucoasei si fibroza ( proliferare de tesut conjunctiv );
D+: enteropatie ulcero – necrotica.
24.
Enterita ulcero-necrotica25.
DD:1. Enterita catarala
- descuamari epiteliale, fara ulceratii.
2. Enterita foliculara a nou-nascutului
- foliculi limfoizi mari, hipertofiati.
3. Enterita purulenta
- numar crescut de PMN.
4. Leziuni ulcerative: TBC, dizenterice
- apar in alte sectoare ale tubului digestiv;
26. BOALA CROHN ( ILEITA TERMINALA )
Definitie: inflamatie cronica, ulcerativa, granulomatoasa ( in 50% ) a pereteluitractului digestiv, ce se extinde discontinuu ( inflamatie segmentara ), oriunde de la
cavitatea bucala la anus, cu evolutie in pusee si recurente frecvente;
- este frecvent localizata in ileonul distal ( numita si ileita terminala );
- se caracterizeaza prin:
• inflamatie transmurala, cu afectarea mucoasei intestinale;
• prezenta de granuloame non-cazeoase
• fisuri, formare de fistule;
- apare la orice varsta, frecvent are 2 varfuri: 20 -30 de ani si la 60-70 de ani;
- femei > barbati;
Etiologie: necunoscuta, probabil de origine virala;
Factor de risc: fumatul;
27.
Macroscopic:Boala Crohn este segmentara cu alternante de mucoasa normala.
1. Mucoasa:
- leziuni ulcerative dispuse longitudinal, in lungul axului digestiv ( ulcere liniare ), aspect “ de domino” al
mucoasei / “piatra de pavaj” ( intrucat, intre ele, mucoasa este normala ) / aspect lichenoid ( datorita
edemului din submucoasa ).
- apar fisuri adanci intre faldurile mucoasei, cu formare de fistule ( entero-enterale, entero-vaginale, enterocutanate );
- pot apare polipi inflamatori.
2. Peretele intestinal:
- este ingrosat, dur, cauciucat ( datorita edemului, inflamatiei, fibrozei si hipertrofiei muscularei propria ),
cu lumen ingustat ( materialul digerat are aspect de coloana subtire );
Rx: lumenul intestinal - “semnul firului” / “semnul furtunului de cauciuc” ( dat de solutia de bariu
extrem de subtire ce trece prin segmentul afectat );
Caracteristic: demarcarea serpuita a segmentului intestinal afectat, fata de zonele din jur neafectate.
- cand sunt prinse mai multe segmente intestinale, intre ele exista zone normale de intestin ( skip lesions );
3. Seroasa:
- este granulara, culoare gri inchisa, acoperita de grasimea mezenterica din jur ( creeping fat );
- mezenterul de la nivelul segmentului afectat este ingrosat, edematos, uneori fibrotic;
- inflamatia seroasei produce aderente;
28.
Boala CrohnBoala Crohn
29.
Microscopic: mucoasa:1. PMN intraepiteliale ( epiteliul de suprafata ), particular agregate
limfoide supraiacent mucoasei;
- PMN infiltreaza epiteliul glandular: criptite / lumenul glandelor:
abcese criptice ( forma activa );
2. vilozitatile intestinale: aplatizate, variabil largite.
3. epiteliul glandular: metaplazie pilorica ( ~ cu celulele antrale
gastrice) / metaplazie de celule Paneth ( se gasesc in mod normal mai
frecvent in intestinal subtire, dar si la nivelul cecului si apendicelui);
4. ulceratia: apare in formele severe, fiind superfciala sau profunda pana
in musculara proprie;
- exista o trecere abrupta intre mucoasa ulcerata si mucoasa normala.
- musculara mucoasei: se dubleaza, fiind ingrosata, neregulata;
5. in corion: infitrat limfo-plasmocitar.
!!! Caracteristic bolii Crohn:
1. infiltratul limfo-plasmocitar transmural dispus difuz ( in toate
straturile peretelui intestinal );
2. agregatele limfoide ( foliculi limfoizi ) transmural, frecvent in
submucoasa si subseroasa;
3. in 50 % cazuri: granuloame non-cazeoase ( sarcoid-like ) dispuse
transmural formate din:
- celule gigante multinucleate cu citoplasma eozinofila si nuclei
marginali in “coroana’;
- celule epitelioide mari, poligonale;
- inconjurate la periferie de limfocite in numar crescut.
4. pot apare fisuri intinse, de la nivelul mucoasei pana in musculara
propria.
30.
Boala Crohn: granulom cu celule gigante dispus inmusculara.
Boala Crohn: fisura, dinspre mucoasa spre
submucoasa.
31.
Boala CrohnMucoasa: infiltrat limfocitar si abcese criptice
Musculara: infiltrat limfocitar si granuloame non-cazeoase
32.
DD: Macroscopic:1. Rectocolita ulcero-hemoragica ( colita ulcerativa )
- boala inflamatorie a colonului si rectului, cu evolutie cronica, cu pusee neinfectioase, ce afecteaza in
principal mucoasa, caracterizata prin zone de ulceratie continua; nu prezinta perete ingrosat.
( rect = proctita; tot colonul = pancolita, cecul: tiflita );
Microscopic:
- ulceratii, criptite, infiltrat inflamator limfo-plasmocitar, cu tesut de granulatie, urmat de fibroza
cicatriciala, cu modificari regenerative ale epiteliului de suprafata ( celule reactive ), ce pot suferi leziuni
displazice si chiar malignizare.
- formare de fistule;
- nu prezinta inflamatie cronica granulomatoasa ( granuloame );
2. Ulceratia tifica
- ulceratie longitudinala a mucoasei cu cicatrice scleroasa;
3. Ulceratia TBC
- ulceratii transversale, cu margini decolate, neregulate, cu depozite galbene, mici, la nivelul bazei;
- seroasa: tuberculi miliari, 1mm, alb- sticlosi, fermi.
DD: Microscopic:
1. Granulomul TBC
2. Granulomul sarcoidozic.
33. APENDICITA ACUTA FLEGMONOASA
Apendicita: inflamatie acuta, exsudativa, purulenta a apendicelui, ce poate fi catarala,flegmonoasa sau gangrenoasa.
- mai frecventa la adolescenti si adultii tineri dar, poate apare la orice varsta.
- mai frecventa la barbati decat la femei.
Cauze:
1. obstructia lumenului de catre:
- coproliti ( materii fecale calcificate );
- mai rar prin tumori ( T carcinoide ), calculi, emboli parazitari ( ascarizi );
2. stafilococi, streptococi, colibacili, anaerobi;
3. necunoscute: fara identificarea factorului oclusiv predispozant, fara a se cunoaste in acest
caz, patogeneza inflamatiei.
Patogenie:
- prezenta obstructiei lumenului apendicular va determina cresterea presiunii intraluminale in
urma cresterii secretiei mucinoase, cu afectarea drenarii venoase si ischemie locala, ce va
favoriza invazia bacteriana, concomitent cu o reactie inflamatorie din partea mucoasei
agresionate;
- se formeaza astfel, un cerc vicios prin agresare ischemica si invazie bacteriana ceea ce,
determina un raspuns inflamator care, la randul sau, va produce hipoxie si exarcerbarea
activitatii bacteriene.
34.
Apendic normalMacroscopic:
- apendice turgescent ( exsudat inflamator ),
tumefiat cu desen vascular accentuat ( hiperemie ).
1. Seroasa: mata, cu luciu sters ( datorita
raspunsului inflamator ) acoperita de depozite albe
de fibrina, de aspect granular;
- mezoapendice edematiat cu desen vascular
accentuat;
2. Pe sectiune: perete ingrosat, friabil;
3. Mucoasa: congestiva, groasa, cu mici picheteuri
hemoragice;
- in lumen: continut purulent, coproliti;
Apendic inflamat
35.
Diagnostic de organ: apendice- organ circular ( cavitar ) cu lumen mic si perete gros.
1. Mucoasa:
- epiteliu de suprafata: celule cilindrice unistratificate
si celule caliciforme ( celule Goblet );
- glande ( glande Liberkuhn ) tapetate de epiteliu de tip
intestinal format din celule cilindrice si celule
caliciforme.
- corion: tesut conjunctiv, limfocite, vase si uneori,
foliculi limfatici cu centrii germinali;
- musculara mucoasei: slab vizibila;
2. Submucoasa: tesut conjunctiv lax, vase, foliculi
limfoizi cu centrii germinali;
3. Musculara: fibre musculare netede dispuse circular
( stratul intern ) si longitudinal ( stratul extern );
4. Seroasa: peritoneul visceral, format din tesut
conjunctv lax si tesut adipos.
36.
Microscopic: apendicita flegmonoasa:Mucoasa
1. in cavitate ( lumen ): exsudat purulent cu PMN,
piocite, detritus necrotic, hematii; uneori, colonii
bacteriene ( daca cauza este si bacteriana );
2. mucoasa: mici ulceratii ale epiteliului de suprafata
( erodarea epiteliului - exulceratie / pierderea epiteliului ),
alterari ale epiteliului glandelor;
Lumen
- in corion: PMN abundente, capilare hiperemiate;
3. submucoasa si musculara: PMN abundente.
Caracteristic apendicitei flegmonoase:
- prezenta PMN transmural ( in tot peretele apendiceal,
pana la nivelul seroasei inclusiv );
Musculara si seroasa
4. seroasa: hiperemie importanta ( vase hiperemiate ), cu
extravazari sanguine ( datorita friabilitatii peretelui
apendiceal inflamat ) si formarea depozitelor de fibrina,
rare PMN.
D+: apendicita acuta flegmonoasa ( pe seama infiltrarii
muscularei cu PMN );
37.
DD:1. Apendicita acuta purulenta catarala
Macroscopic: mucoasa este hiperemiata, edematiata, cu zone mici de necroza la
nivelul pliurilor si exsudat purulent in lumen ( afectul primar apendicular Aschoff );
Microscopic: PMN doar la nivelul mucoasei.
2. Abcesul apendicular
- colectie localizata purulenta ( PMN ) la nivelul seroasei.
3. Apendicita perforata ( supurata )
- puroi in lumen si in foliculii limfatici, fistula de la nivelul mucoasei pana la
seroasa,
seroasa cu depozite de fibrina;
4. Apendicita cronica acutizata
- inflitrat limfocitar abundent, cu prezenta de PMN si eozinofile;
38. ADENOCARCINOMUL DE COLON ( ADK )
Definitie: TM epiteliala a mucoasei colonice, cu diferentiere glandulara ( ADK );- a II-a cauza de deces, dupa carcinomul pulmonar ( la barbati ) si cel mamar ( la femei ).
- apare la varsta de 60 – 79 ani; in 20 % din cazuri la cei pana in 50 de ani ( la cei cu polipoze erediatre );
Localizare: - 50 % - colon drept;
- 60 – 70 % - rect / recto-sigmoidian;
Macroscopic:
T. colon proximal ( colon drept ):
- masa polipoida, exofitica, vegetanta / conopidiforma ce proemina in lumenul intestinal, extinzandu-se
de-a lungul peretelui cecal si al colonului ascendent;
- obstructia lumenului este rara;
T.colon distal ( colon stang ):
- placi inelare gri-rozate ulcerate, aspect de crater, cu margini neregulate, dure, proeminente,
anfractuoase, inghesuite ( anfractuoase ), cu aspect de “matanii”, ce produc ingustarea lumenului si
posibil dilatarea intestinului proximal; pot fi insa si insidios infiltrative ( greu de identificat Rx si
macroscopic ); sunt mai agresive si dau metastaze in stadiul incipient;
- ambele pot avea diferite dimensiuni, consistenta elastica, cu zone de necroza si hemoargie;
- ambele, pot perfora peretele intestinal si in timp ( ~ ani ) sa formeze mase tumorale mari, ferme, albe la
nivelul seroasei, ganglionhilor limfatici regionali;
39.
ADK colon: forma polipoidaADK colon: forma ulcerata, crateriforma
ADK colon: forma vegetanta
ADK colon: forma ulcerata, crateriforma
40.
Diagnostic de organ: colon.4 structuri:
1. Mucoasa:
- neteda, fara vilozitati;
a) epiteliul de acoperire: simplu cilindric,
format din celule de absorbtie si celule
caliciforme ( celule Goblet );
- glande colice ( cripte ) Lieberkuhn;
b) lamina propria ( corion ): tesut conjunctiv
lax cu limfocite, plasmocite, fibre nervoase, vase;
2. Submucoasa:
- tesut conjunctiv lax cu fibroblaste, rare
adipocite, vase, nervi;
3.Musculara:
- fibre musculare netede dispuse circular si
longitudinal;
4.Seroasa:
- peritoneul visceral, tesut adipos.
41.
Microscopic: ADK G1 / G2Mucoasa:
1. proliferare de celule tumorale maligne cu punct de plecare in epiteliul
glandular / epiteliul de suprafata cu dispunere glandulara, dispuse initial in
mucoasa, cu invazia submucoasei, muscularei si chiar a seroasei;
- trecerea de la celulele mucoasei colonice normale la celulele tumorale este
brusca.
Glandele tumorale neregulate, ramificate dispuse in toate directiile, tapetate
de epiteliu cilindric inalt, stratificat cu atipii cito-nucleare: nuclei mariti de
volum, intens hipercromi, pleomorfi, cromatina grunjoasa, nucleoli prezenti, cu
numeroase mitoze atipice;
! - nu mai sunt prezente celulele caliciforme.
! - celulele tumorale nu au membrana bazala;
- lumenele glandelor: sunt inguste / ectaziate ( dilatate );
- uneori, epiteliul tumoral poate prezenta proliferari papilare in lumenul
glandular ( ADK tubulo-papilar / tubulo-papilifer );
- celulele tumorale pot secreta mucina dispusa intraluminal / interstitial ( in
stroma ): ADK de colon cu diferentiere mucinoasa.
- daca, mucina extracelulara depaseste 50 % din suprafata: ADK de colon
mucinos.
pTNM:
- ADK invaziv: submucoasa ( T1 ), musculara ( T2 ), seroasa si tesutul adipos
periseroasa ( T3 );
2. stroma:
- in jurul glandelor tumorale: stroma desmoplazica, ( fibroasa )cu limfoplasmocite;
- pot fi prezente zone de necroza si hemoragie.
42.
ADK de colon43.
Gradul de diferentiere histologica:G1, G2, G3.
- cand T formeaza preponderent glande:
ADK bine diferentiat ( G1 ).
- cand proliferarea tumorala formeaza
mai putine glande si se dispune si sub
forma de zone solide: ADK moderat
diferentiat ( G2 ).
- cand T formeaza extrem de putine
glande / deloc, cu predominanta zonelor
solide, infiltrative: ADK slab
diferentiat / nediferentiat ( G3 );
foarte agresiv;
44.
DD:1. ADK mucinos ( coloid mucos )
- mucina dispusa extracelular, atat
in lumenul glandelor tumorale, cat
si in stroma ( in proportie de peste
50 % );
2. ADK adeno-scuamos
- focare de diferentiere tumorala
scuamoasa si glande tumorale;
ADK colon mucinos
ADK colon adenoscuamos

medicine
medicine








